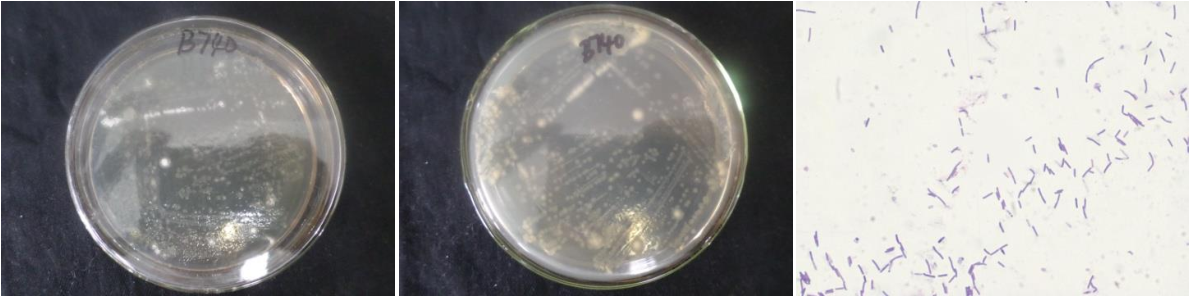

Loading...
| StrainNO | B740 |
| Classification | Bacillus |
| 16s rDNA sequence | GCCGGCGCATGCTATACATGCAGTCGAGCGGAGTTAAAGGAGCTTGCTCCTTTAACTTACGGCGGACGGGTGAGTAACACGTGG GTAACCTGCCTGTAAGATCGGGATAACTCCGGGAAACCGGGGCTAATACCGGATAACATCAAAAGCTGCATGGCTTTTGATTGA AAGGCGGCTTCCGCTGCCGCTTACAGATGGACCCGCGGCGCATTAACTAATTGGTGAGGTAACGGCTCACCAAGGCCACGATGC GTAACCGACCTGAAAGGGTGATCGGCCACACTGGGACTGAAACACGGCCCAAACTCCTACGGGAGGCAGCAGTAAGGAATCTTC CGCAATGGACGAAAGTCTGACGGAACAACGCCGCGTGAGTGAAGAAGGTTTTCGGATCGTAAAACTCTGTTGTCAGGGAAGAAC AAGTACGGGAGTAACTGGCCGTACCTTGACGGTACCTGGCCAGAAAGCCACGGCTAACTACGTGCCAACAGCCGCGGTAATACG TAGGTGGCAAGCGTTGTCCGGAATTATTGGGCGTAAAGCGCGCGCAGGCGGTCTTTTAAGTCTGATGTGAAAGCCCACGGCTCA ACCGTGGAGGGTCATTGGAAACTGGAAGACTTGAGTGCAGAAGAGAAGAGCGGAATTCCACGTGTAGCGGTGAAATGCGTAGAG ATGTGGAGGAACACCAGTGGCGAAGGCGGCTCTTTGGTCTGTAACTGACGCTGAGGCGCGAAAGCGTGGGGAGCGAACAGGATT AGATACCCTGGTAGTCCACGCCGTAAACGATGAGTGCTAAGTGTTGGGGGGTTTCCGCCCCTCAGTGCTGCAGCTAACGCATTA AGCACTCCGCCTGGGGAGTACGGCCGCAAGGCTGAAACTCAAAGGAATTGACGGGGGCCCGCACAAGCGGTGGAGCATGTGGTT TAATTCGAAGCAACGCGAAGAACCTTACCAGGTCTTGACATCCCGCTGACCGGCATGGAGACATGTCTTCCCCTTCGGGGGCAG CGGTGACAGGTGGTGCATGGTTGTCGTCAGCTCGTGTCGTGAGATGTTGGGTTAAGTCCCGCAACGAGCGCAACCCTTGATCTT AGTTGCCAGCATTCAGTTGGGCACTCTAAGGTGACTGCCGGTGACAAACCGGAGGAAGGTGGGGATGACGTCAAATCATCATGCCCCTTATGACCTGGGCTACACACGTGCTACAATGGATGGTACAAAGGGCTGCAAGACCGCGAGGTTTAGCCAATCCCATAAAAC CATTCTCAGTTCGGATTGCAGGCTGCAACTCGCCTGCATGAAGCTGGAATCGCTAGTAATCGCGGATCAGCATGCCGCGGTGAA TACGTTCCCGGGCCTTGTACACACCGCCCGTCACACCACGAGAGTTTGCAACACCCGAAGTCGGTGGGGTAACCCTTACGGGAG CCAGCCGCCGAAGGTGGTCAGG |
| Strain Morphology Photos | |
| Morphological Description | The morphology of Colony round;milky white;edge neatly;flat;concentric ring;center bulge;slippy;sticky;waxy;The morphology of strain:Rod;having spore;terminal spore |